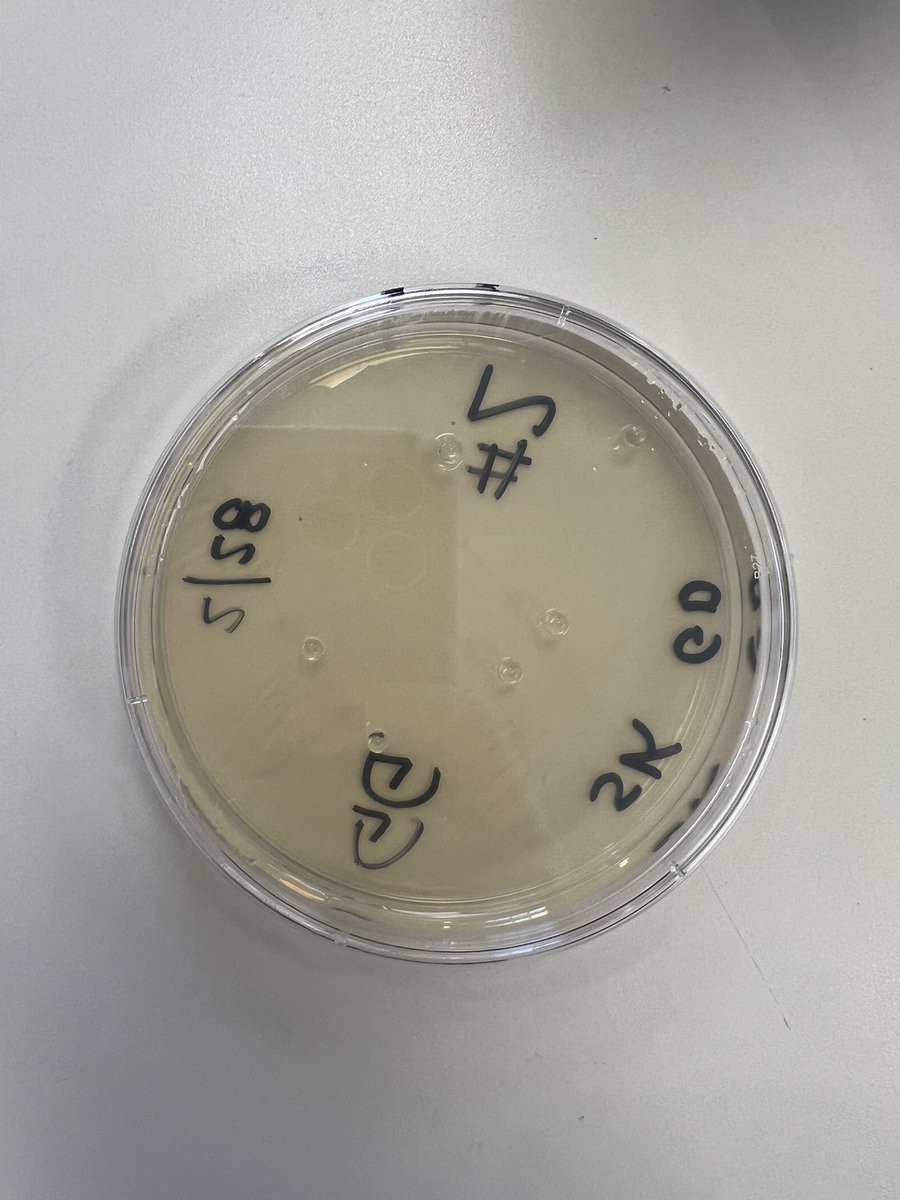
The 8th graders visited the DNA Learning Center in Cold Spring Harbor today.  They attended 3 workshops where they learned how DNA is used to solve mysteries and how to genetically modify (harmless) bacteria. 🧬🦠🧫<a href="/LomsPrincipal/">LOMS Principal</a>

Mrs. Krukas
@krukasmath
8th Grade Math Teacher➕Algebra 1 Teacher➕Mom of 3➕Currently Obsessed with Desmos➕Anything Math Related 👩🏫💜🧮📈
ID: 1374550504466972675
24-03-2021 02:36:01
27 Tweet
63 Followers
73 Following

LOMS Algebra 1 students analyzed the work of others while completing a multi-step equations carousel. Each student solved a step then passed it to the next person. It was a great way to practice finding and explaining mistakes! ✅❎LOMS Principal #mistakesallowthinkingtohappen







Had a great time at Adventure Park Long Island with the LOMS 8th graders! 🧗♀️🍂🌳LOMS Principal

Students in 8th grade completed a math carousel yesterday where they moved from station to station completing problems about linear functions while checking for errors in their classmates’ work. LOMS Principal






Happy 100th day of school! Cannot pass up an opportunity to celebrate this great number! ✏️➕➖➗✖️🟰💯 How many expressions can you make that total 100?! LOMS Principal


The 8th graders had a great time exploring science at the Big Science Day today! 🧼🔎⚡️🫧🚀 LOMS Principal



The 8th graders visited the DNA Learning Center in Cold Spring Harbor today. They attended 3 workshops where they learned how DNA is used to solve mysteries and how to genetically modify (harmless) bacteria. 🧬🦠🧫LOMS Principal

A show so good I went to go see it again! Congrats to the LOMS performers of Shrek Jr! Another amazing performance! 💚 LOMS Principal


What’s the secret to “The Magic Circle”? 🔮Only LOMS 8th graders know! Today, students made their own magic ‘circles’, and period 3 enjoyed a board game period♟️after earning it for their impressive i-Ready assignment completion! LOMS Principal


Congrats 🎉 to the 2023 LOMS 8th graders on their graduation!! We finally made it to day 180 out of 180! What a fantastic year it was and I wish them all the best in the future! 💯🎓☀️LOMS Principal








